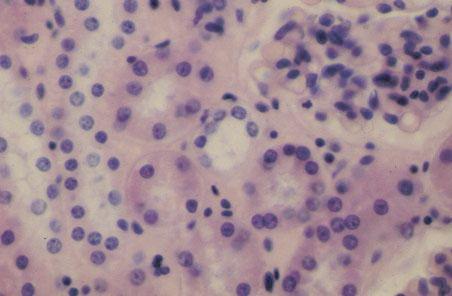

previous / next
return to index
previous / next
return to index
X-5 (4) Slide 85, Human Kidney (H&E). High power view of glomerulus, proximal convoluted tubules (eosinophilic lining cells with fuzzy lumen), and distal convoluted tubules (light staining cells with larger lumen).